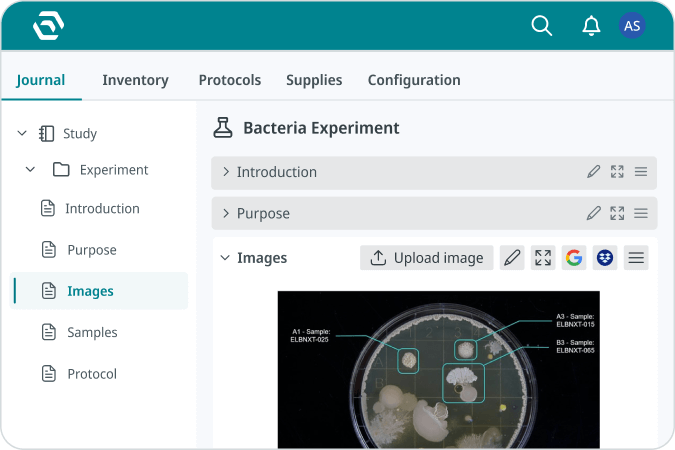
Image

Your home base for connected and reproducible science
Unite research, lab operations, safety, and compliance
so teams can work with clarity and confidence.


Trusted by 550,000+ scientists, EHS, and LabOps worldwide in 55,000+ laboratories
“Working with the SciSure team has been a collaborative and productive experience.”
Customer story
"SciSure helps us save time by enabling us to share our protocols with colleagues easily. It also takes care of our sample management."
“I'm thoroughly impressed with how SciSure has transformed our daily operations.”
“SciSure cuts down time and energy spent on tasks. I’ve loved working with it.”
“We’ve replaced Excel, paper, and Access databases with efficiency, turning manual tasks from hours into minutes.”
G2 Leader Across Enterprise, Mid-Market & SMB
THE SCIENTIFIC MANAGEMENT PLATFORM (SMP)
The core capabilities behind your digital lab
Discover a Scientist Experience designed to empower science.
ELN
Capture your discoveries as they happen, with structure that protects your science and preserves every insight.
LIMS
Know where every sample lives, how every resource is used, and trust the data behind every decision.

Health & Safety (EHS)
Create a lab environment where people feel protected, prepared, and empowered to work safely.

Integrations
Extend your platform with integrations and apps that adapt to how your lab works best.

Connect your research
NO MORE SILOS
Built for every lab, designed for every role

Accelerate research and ensure data integrity
Focus on discovery, not documentation
Centralized experiment management and version control.
Automated compliance–never lose critical data.
Intuitive workflows that enhance reproducibility.

Less scrambling, more control
Run a smooth and efficient lab. No more last-minute chaos.
Streamlined inventory and resource management.
Automated workflows, approvals, and reporting.
Real-time analytics for better decision-making.

Compliance, without the headaches
Ensure audit readiness and keep your lab aligned with industry regulations
Automated safety checks and real-time tracking.
Regulatory-ready documentation–no last-minute scrambles.
Built-in adherence to ISO, FDA 21 CFR Part 11, HIPAA, and GxP.

Secure, scalable, seamless
A future-proof solution that integrates easily, keeps data secure, and scales without adding IT overhead.
API-friendly and integrates with existing systems.
Cloud-based security with controlled access.
Scales with your lab without extra IT overhead.

Future-proofing research excellence
Drive innovation and operational efficiency with a platform that enhances scientific impact while reducing costs
Reduced operational costs with smarter automation.
Improved data integrity and scientific impact.
A research-driven culture without administrative burdens.
DATA SECURITY & COMPLIANCE
Secure, compliant, and built for trust
SciSure is built with compliance at its core. We ensure your lab meets the highest standards of security and regulatory adherence, so you never have to second-guess your compliance readiness.
ISO/IEC 27001 certified
International standard for data security management.
HIPAA
Secure handling of patient health information.
FDA 21 CFR Part 11
Full compliance for electronic records.
GxP
Adherence to Good Laboratory Practices (GLP) and other regulatory standards.
GDPR
All personal data is collected, stored, and processed securely and transparently.
SOC 2 Type II
Industry-leading certification ensuring robust security, availability, and privacy controls.
Real labs. Real results.
Tangible outcomes from teams transforming their lab operations.
Build a stronger lab with SciSure
Unify your systems, protect your people, and gain full visibility across your operations with a platform designed for modern scientific organizations.












